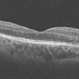

-
 By Priya Rasipuram Chandrasekaran, MBBS, DO, DNB, FRCS
By Priya Rasipuram Chandrasekaran, MBBS, DO, DNB, FRCS
Lotus eye hospital
Co-author(s): Lotus eye hospital, Salem, India - Uploaded on Apr 26, 2021.
- Last modified by Caroline Bozell on Apr 27, 2021.
- Rating
- Appears in
- Miscellaneous
- Condition/keywords
- spontaneous retinal reattachment, re-attached retinal detachment (RRD)
- Imaging device
- Fundus camera
- Description
- This is the fundus photo montage and red free montage of a 27-year-old male showing pigmentary changes and atrophic changes in the inferior retina involving the macula. This has sharply demarcated margins and a convex border with subretinal bands suggestive of spontaneous reattachement of retinal detachment.


 Initializing download.
Initializing download.